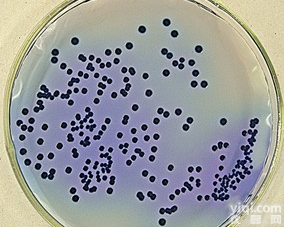
改良的<em>酵母</em>浸汁-<em>孟加拉</em>红<em>肉汤</em>変法<em>酵母</em>エキスーベンガルブイヨン

改良的酵母浸汁-孟加拉红肉汤 改良的酵母浸汁-孟加拉红肉汤价格
- 产地:欧洲
- 供应商:上海诺渊实业有限公司
- 供应商报价:电议
- 标签:改良的酵母浸汁-孟加拉红肉汤 改良的酵母浸汁-孟加拉红肉汤价格,生物试剂,通用试剂,供应改良的酵母浸汁-孟加拉红肉汤 改良的酵母浸汁-孟加拉红肉汤价格,上海诺渊elisa试剂盒,培养基,标准品专卖
产品中文:改良的酵母浸汁-孟加拉红肉汤
产品英文:Modiffied Yeast Extract-Rose Benga Broth
产品货号:10605
产品规格:250g/瓶
产品用途:用于小肠结肠炎耶尔森氏菌增菌